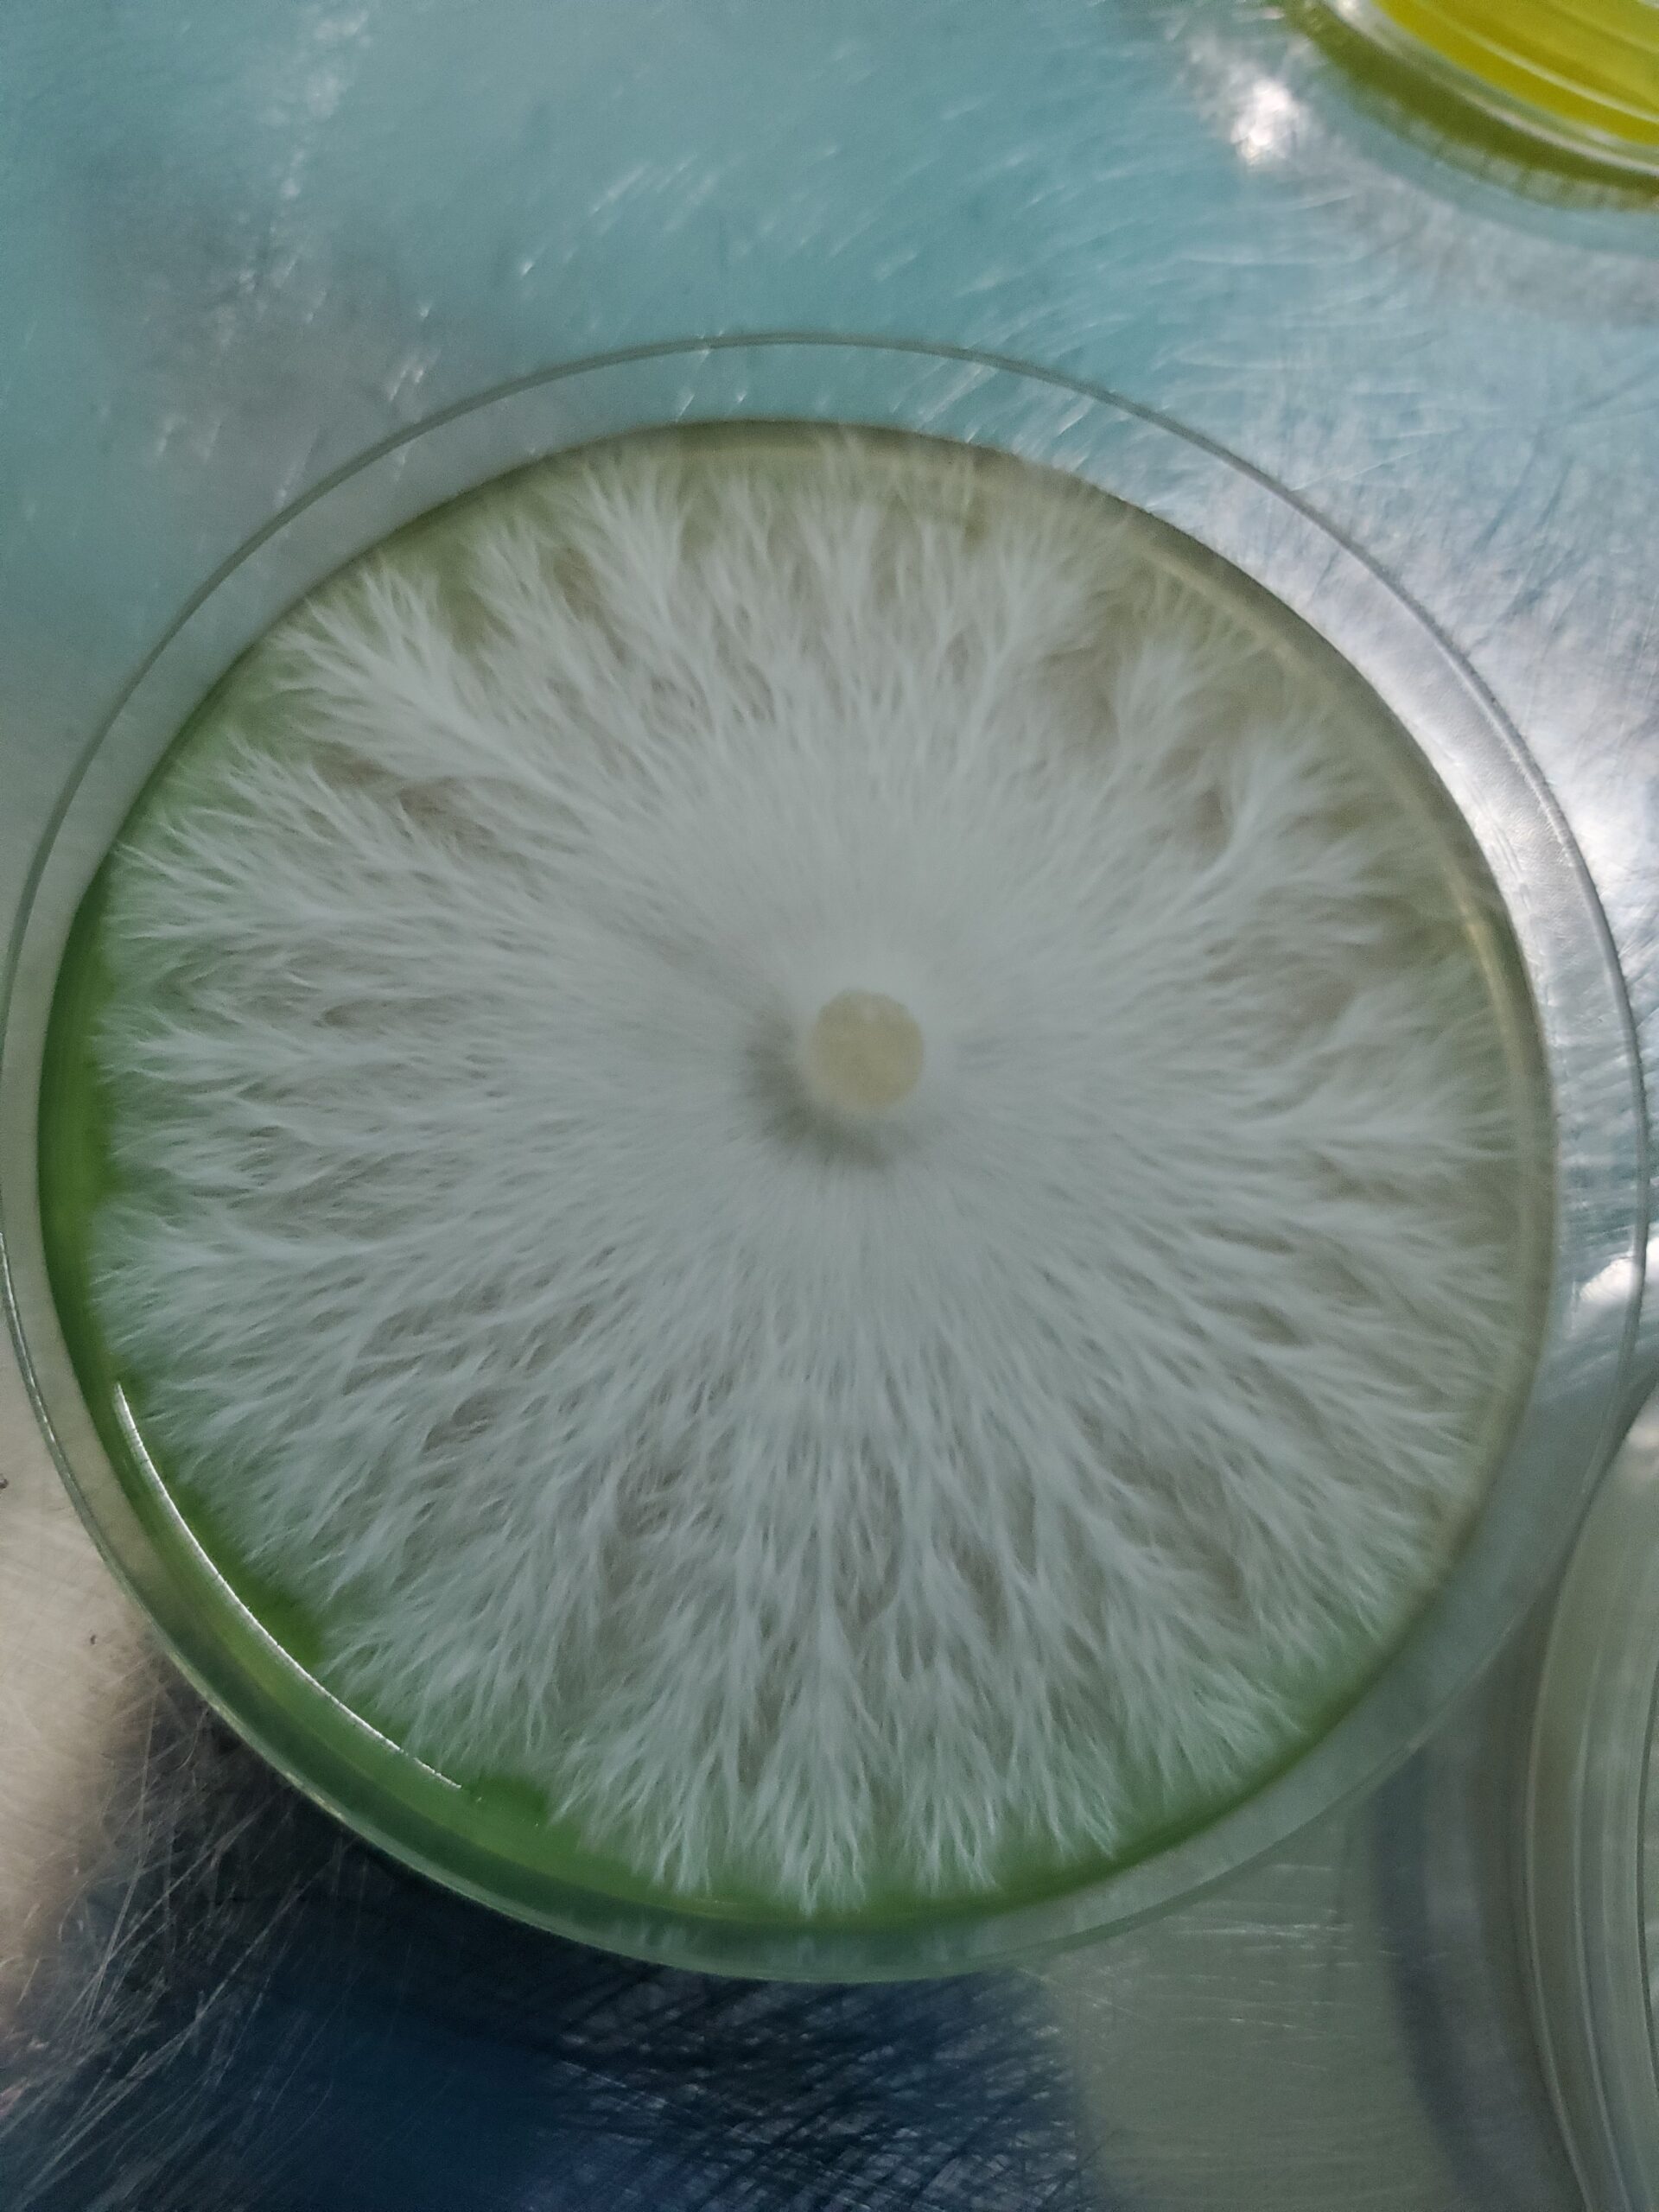

PsyTeam United
Space Monkey Research Plate 100mm
$20.00
Space Monkey
Sv-10 x Makilla Gorilla
Space Monkey is the 4th hybridization project flrom PT U. Space Monkey was named by just mixing the names of SV which essentially means flying saucer in French with Makilla GORILLA. SPACE MONKEY. They resemble Sv-10 more than their other parent, however the MKG genetics seem to make the stripes much more dense than its Sv-10 parent. This variety does very well in resistance against contamination and can withstand very high fruiting temperatures. This is one of our varieties that does amazing under stress and in non ideal environments. Which makes this variety very good for beginners!
Space Monkey has been worked to F6.
Units Sold: 9
Privacy Policy
Please refer to sporeswaps.com for the “Privacy Policy”.
Terms and Conditions
Please refer to sporeswaps.com for the “Terms & Conditions”.
Shipping costs
| Shipping from | United States (US) |
| Within United States (US) | $7.50 |
| Outside United States (US) | $20.00 |
National Shipping Details
| Minimum shipping charge per order | $7.50 |
| Maximum shipping charge per order | $7.50 |
| Free shipping if the order spend is over | $125.00 |
International Shipping Details
| Minimum shipping charge per order | $20.00 |
| Maximum shipping charge per order | $20.00 |
| Free shipping if the order spend is over | $250.00 |